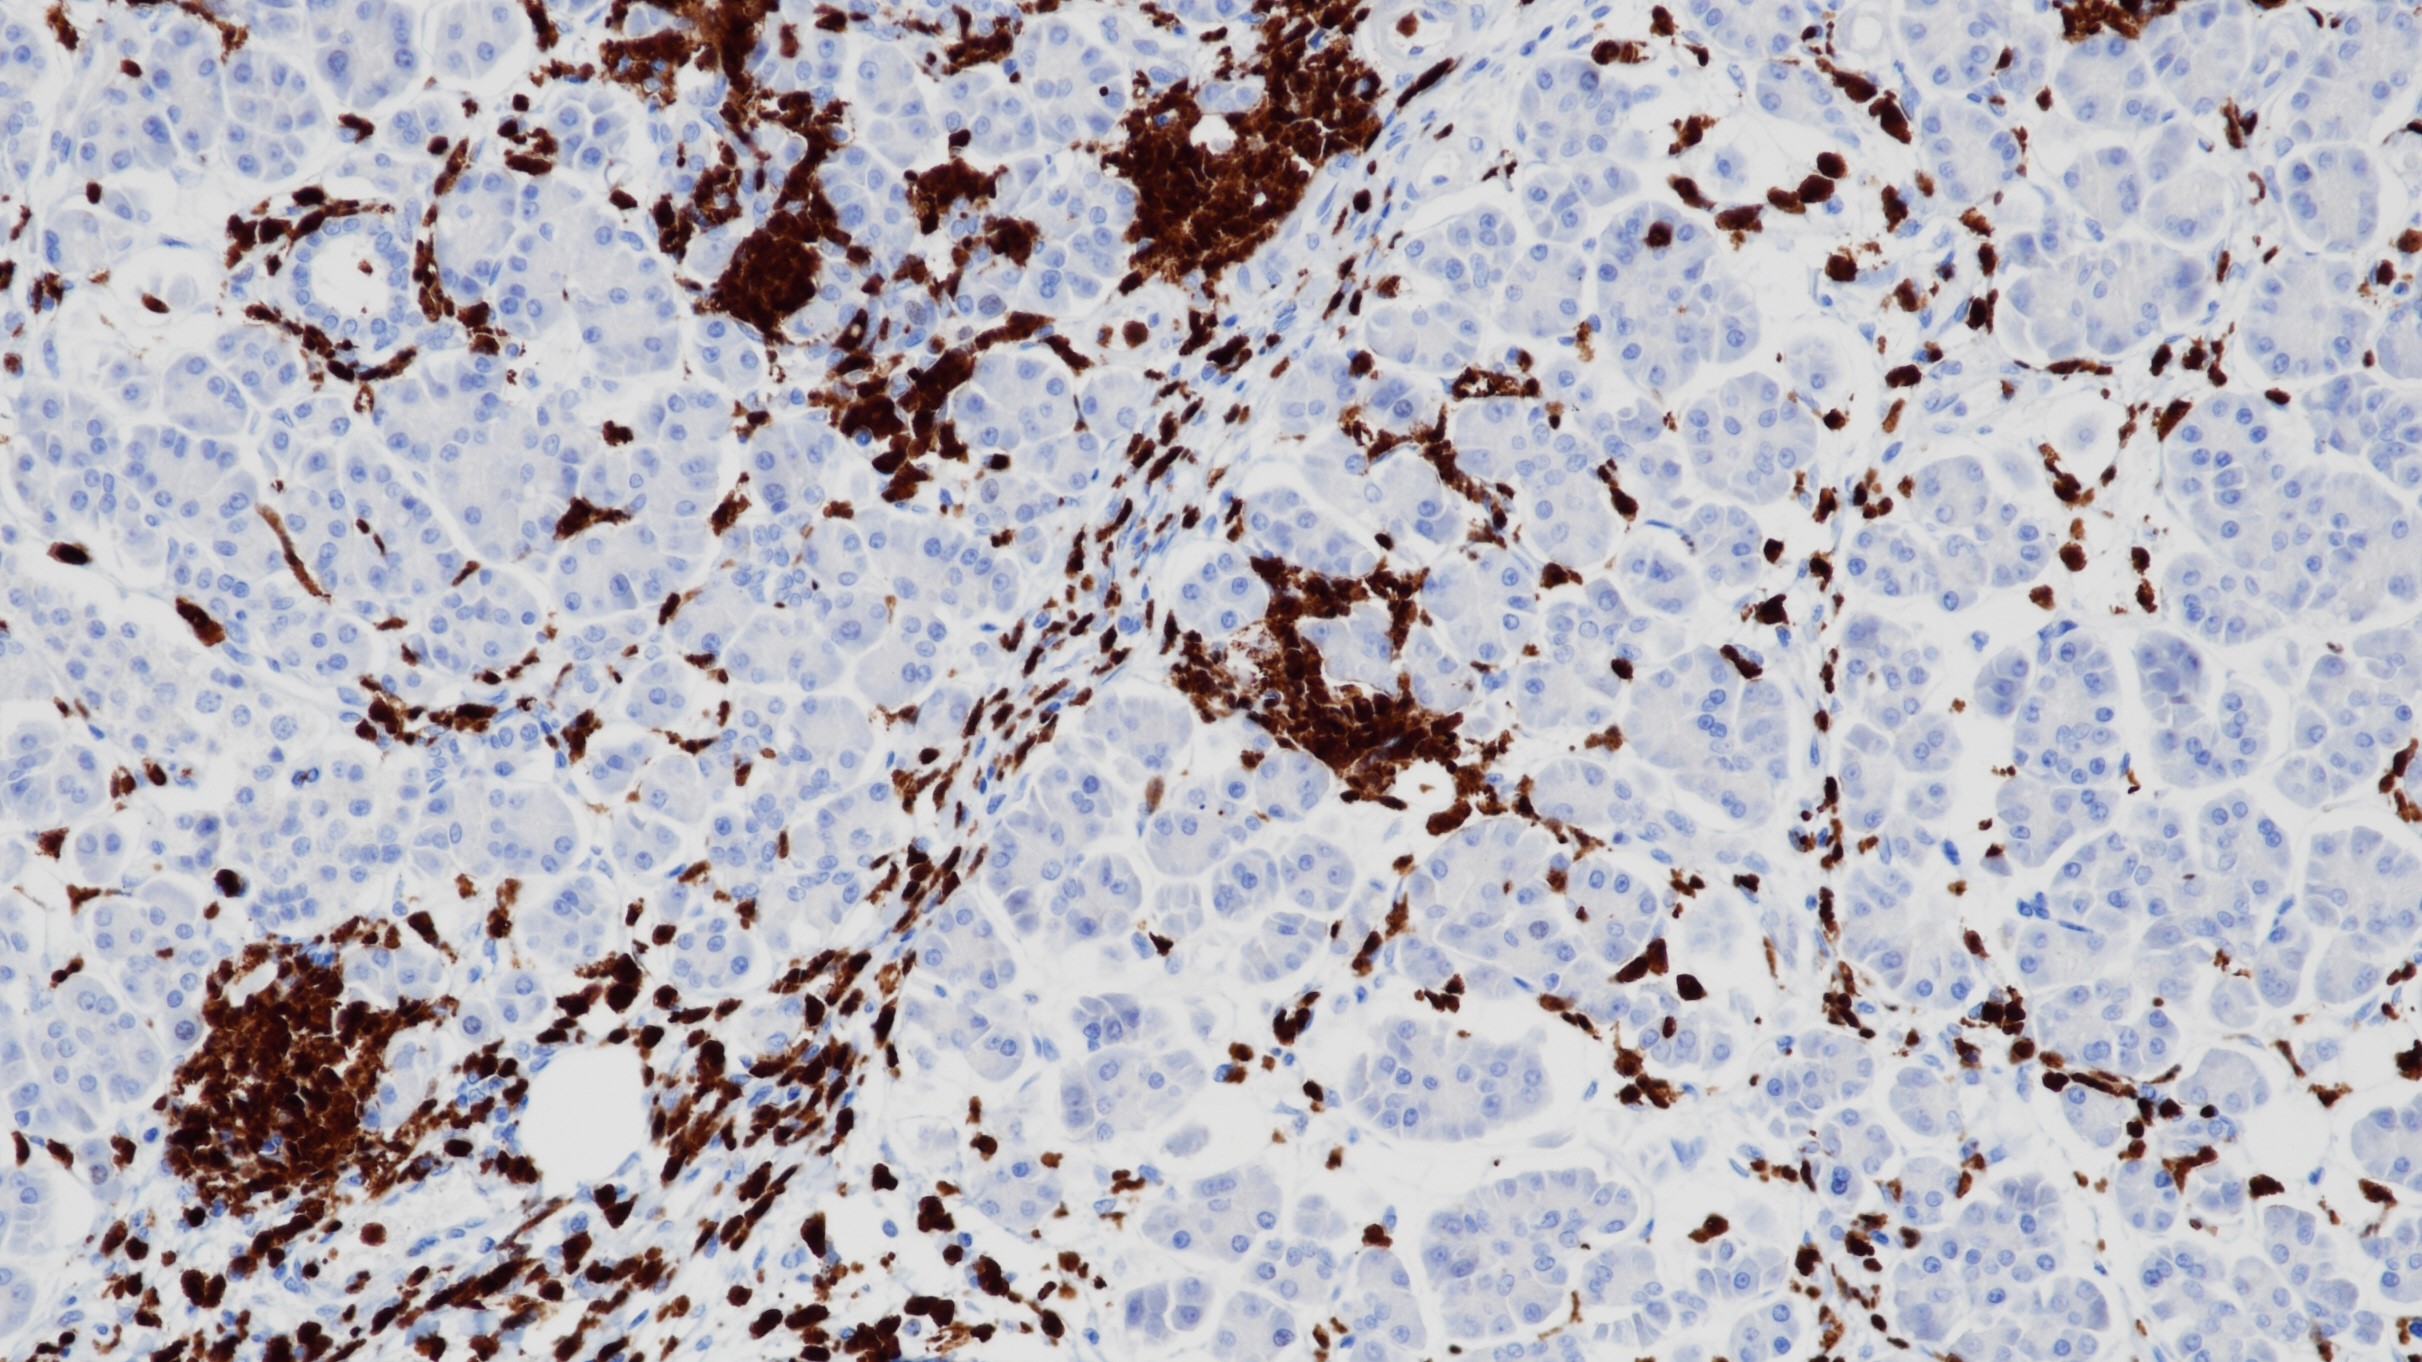
胰腺S100P(BP6018)染色

1. Lin F, et al. Diagnostic utility of S100P and von Hippel-Lindau Gene Product (pVHL) in Pancreatic Adenocarcinoma-with Implication of their Roles in Early Tumorigenesis. Am J Surg Pathol. 2008; 32:78-91.
2. Deng HB, et al. Usefulness of S100P in Diagnosis of Adenocarcinoma of Pancreas on Fine-needle Aspiration Biopsy Specimens. Am J ClinPathol. 2008; 129:81-8.
3. 中华医学会.《临床技术操作规范·病理学分册》.人民军医出版社,2004.